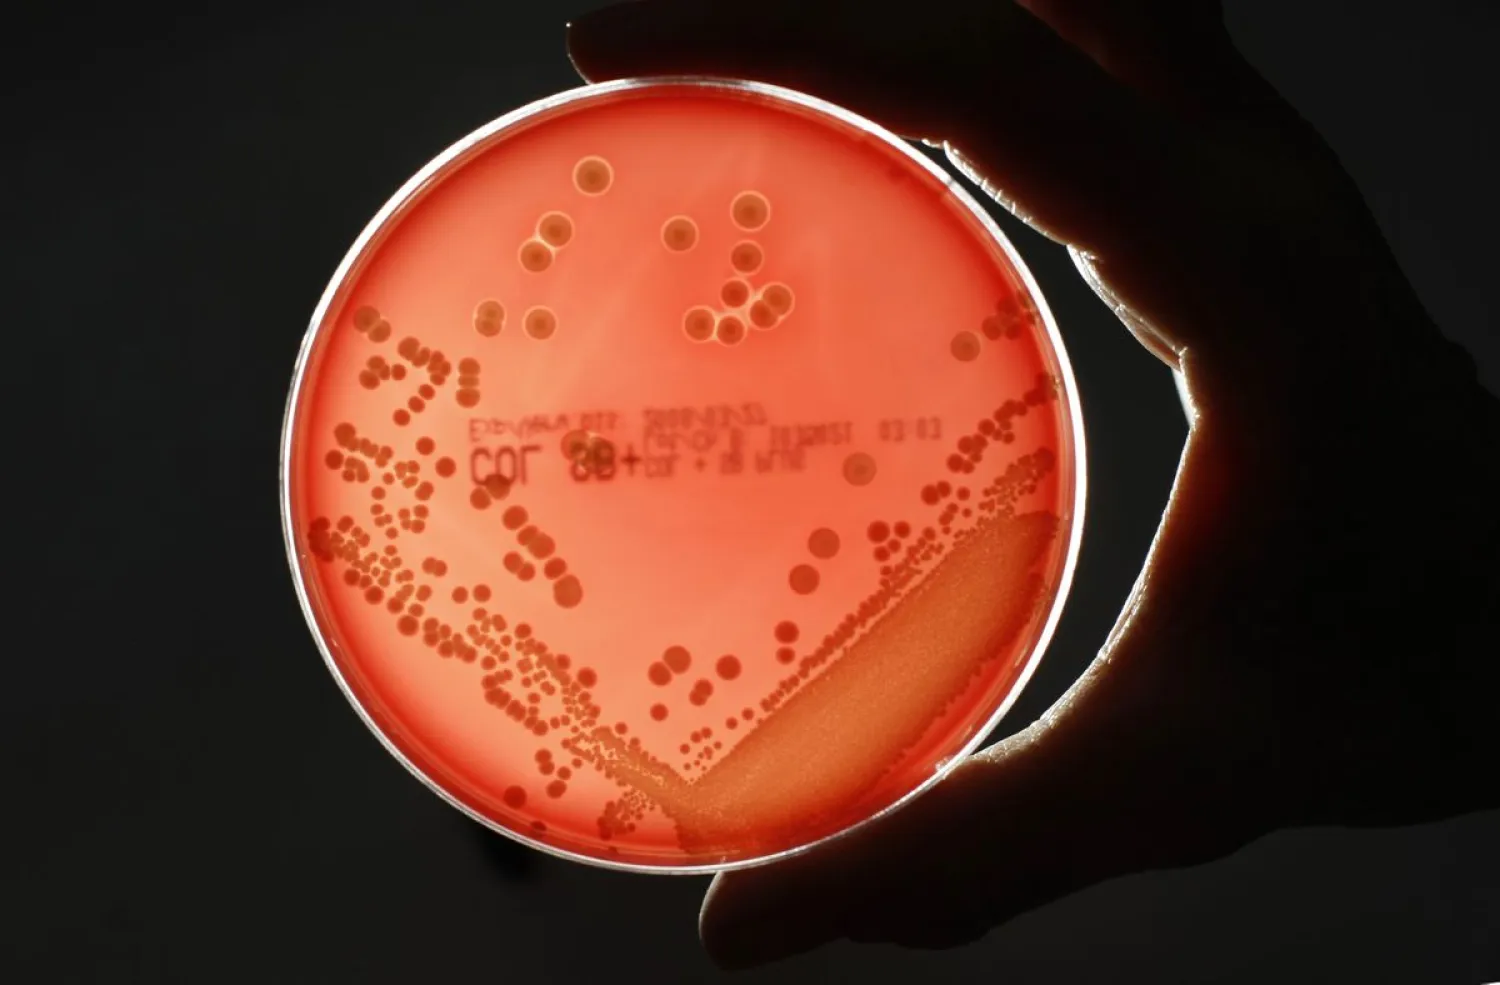
MRSA (Methicillin-resistant Staphylococcus aureus) bacteria
strain is seen in a petri dish containing agar jelly for bacterial
culture in a microbiological laboratory in Berlin March 1, 2008.
REUTERS/Fabrizio Bensch

Bugged by freeloaders? You are not alone. In fact, it is not uncommon in the bacteria world too, where some species of bacteria show keenness to spot the selfish ones among them and punish them, even if the punishment affects the future of group.
Humans need communication to coordinate functions, and so do bacteria; they communicate with each other to sense their population density through a bunch of chemical signals known as "quorum sensing". The population density sensed by the bacteria with the help of these signals is responsible for regulating several behaviors such as resistance to antibiotics.
In a study published July 30 in the journal PLOS Computational Biology, researchers at Britain’s York University discovered that bacterial colonies might go to the extent of harming themselves just to get rid of freeloaders by using “quorum sensing” signals as a tool.
During the study, the researchers described how quorum sensing regulates the supply of shared resources, such as enzymes that break down a food source into useful nutrients. When freeloaders take the nutrients without producing enzymes, they found the cheaters can be punished even though the entire community suffers—much like canceling a banquet when an uninvited guest sneaks in.
"It's costly for a bacterium to contribute to the community, so for a selfish individual, it's best to simply take what's offered without giving anything back. But obviously this is bad for everyone, so the community needs a way to discourage bad behavior," explains lead author Alex Moffett, a York University postdoctoral fellow.
Moffett and his colleagues found that instead of relying on the honor system, these microorganisms used quorum sensing to suppress the freeloaders.
The mathematical modeling used by the researchers showed that quorum sensing plays an important role in bacterial infection such as the lung infections that affect sufferers of cystic fibrosis, so the research team hopes to apply results of this study to understand and disrupt such diseases.
"This will help us understand how bacteria can colonize the lungs so effectively, which might point the way to new treatments," adds Moffett.